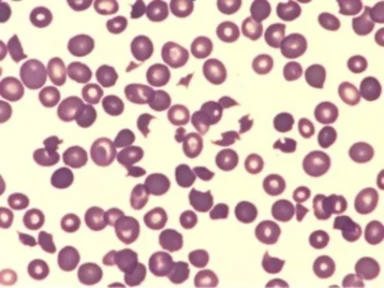

Early diagnosis and treatment of Thrombotic thrombocytopenic purpura (TTP) can help prevent the high risk of early deaths.

TTP is rare and presents similarly to other thrombotic microangiopathies (TMAs), making it difficult to diagnose.
Du er ved at forlade campus.sanofi/dk. Sanofi er ikke ansvarlig for indholdet af dette eksterne websted.
Denne hjemmeside indeholder kun information, der er rettet mod sundhedspersoner. Bekræft venligst nedenfor for at modtage information, film, podcasts og andet materiale.